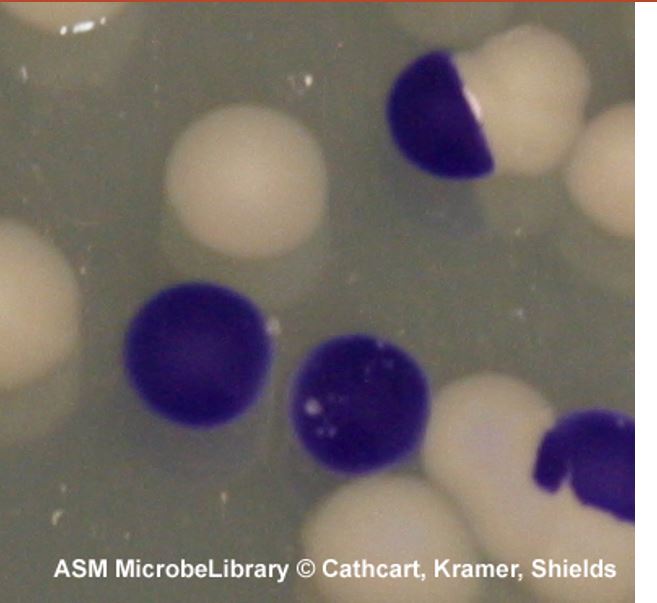

Malonat Kullanımı
I.-Prensip
Malonate besiyeri enterik basillerin malonate kullanımını test etmeye yarayan bir besiyeridir. Besiyeri içinde bulunan maya özütü ve dekstroz bazı bakterilerin üremesini kolaylaştırmak amacıyla eklenmiştir. Karbon kaynağı olarak sodyum molanatı, nitrojen kaynağı olarak amonyum sülfatı kullanabilen bakteriler reaksiyon sonunda sodyum hidroksit oluşumuna bağlı olarak ortamı alkali hale getirirler. Besiyeri içinde bulunan bromtimol mavisi renk değiştirerek besiyerinin mavi renge dönüşmesini sağlar. Malonat kullanımının olmadığı koşulda ise ortam pH’sının değişmemesi nedeniyle besiyeri rengi aynı kalır, ya da besiyeri içinde bulunan dekstrozun kullanımına bağlı olarak oluşan asidik ortam nedeniyle besiyeri rengi sarıya döner.
II.-Besiyerleri ve Ayıraçlar
| Ewing Modifiye Malonate Buyyonu | |
| Maya özütü | 1 g |
| Ammonium sulfate | 2 g |
| Dipotassium phosphate | 0,06 g |
| Monopotassium phosphate | 0,04 g |
| Sodium chloride | 3 |
| Sodium molanate | 2 g |
| Dekstroz | 0,25 g |
| Bromthymol blue | 0,025 g |
| Distile su | 1 L |
III.-Kalite Kontrol
A- Pozitif kontrol: Enterobacter aerogenes ATCC 13048
B- Negatif kontrol: Escherichia coli ATCC 25922
IV.-Yöntem
Test edilecek bakterinin saf ve taze kültüründen 1 koloni alınarak malonate besiyerine ekimi yapılır. Test tüpleri 35 ºC’ de 24-48 saat inkübe edilir.
V.-Sonuçların Değerlendirilmesi
Enterobacter, Klebsiella ve Citrobacter cinsi içinde hemen hemen tüm türler malonatı kullanarak ortamın pH’sının yükselmesine neden olmaktadır. Oluşan alkali ortam nedeniyle pH indikatörü renk değiştirmekte ve besiyerinin maviye dönüşmesine neden olmakta ve test sonucu “pozitif” olarak değerlendirilmektedir. Malonat kullanımının gerçekleşmediği durumda ortam besiyerinde az miktarda bulunan dekstrozun fermentasyonuna bağlı olarak asidik hale gelecek ve pH indikatörü nedeniyle besiyeri rengi sarıya dönüşecek ya da aynı kalacaktır. Bu durumda test “negatif” olarak değerlendirilmektedir.
MUG (4-Methylumbelliferyl-β-D-Glucuronide) Testi
I.-Prensip
Escherichia coli ve diğer bazı Enterobacteriaceae üyeleri ( Salmonella, Shigella ve Yersinia) β-glukuronidaz enzimi sentezlerler. Bu enzimin substratı, 4-methylumbelliferyl-β-D-glucuronide (MUG)’dir. Reaksiyon sonunda 4-methylumbelliferone oluşmaktadır. Bu ürün uzun dalga boyuna sahip UV ışığı altında mavi floresan vermektedir. Escherichia coli suşlarının %97’si β-glukuronidaz enzimine sahip olduğu için, MUG testi klinik örneklerden sıklıkla izole edilen E.coli’nin hızlı tanısında kullanılabilir. Verotoksin üreten E.coli suşları, MUG negatif olan nadir E.coli suşları arasında yer almaktadır. Dolayısıyla, fekal E.coli suşlarında MUG testinin negatif olması, mikrobiyologları olası verotoksin üreten bir E.coli suşuna karşı uyarabilir.
II.-Besiyerleri ve Ayıraçlar
| Sorensen fosfat tamponu: | ||
| A Solüsyonu | B Solüsyonu | |
| Na2HPO4 | 4,73 g | |
| KH2PO4 | 535 g | |
| Steril Distile Su | 500 ml | 500 ml |
| Kullanılacak tampon | 85 ml | 15 ml |
| MUG Adi Besiyeri | |
| Et ekstresi | 3 g |
| Pepton | 5 g |
| MUG | 0,1 |
| Agar | 15 |
| Distile su | 1 L |
MUG Stok Hazırlanması :
Elli miligram MUG tartılarak bir tüpe alınır. Üzerine eriyinceye kadar DMSO eklenir. Daha sonra üzerine 100 ml’ye tamamlayacak kadar Sorensen’s tamponu konur. Bu stok solüsyonda 500 µg/ml MUG bulunmaktadır. Stok solüsyon mikrosantrifüj tüpleri içine dağıtılarak -20°C’de 1 yıl, +4 °C’de 1 hafta saklanabilir. Buzdolabında saklanacak stok solüsyonlar mutlaka alüminyum folyo ile kapatılarak ışıktan korunmalıdır
MUG disklerinin hazırlanması :
MUG stok solüsyonundan 0,2 mL alınarak 3,2 ml tampon çözeltisi içine konulur. Bu şekilde MUG’un 1:16 dilüsyonu yapılır.Steril bir tüpe 50 adet steril boş 6mm’lik kağıt diskler konur. Üzerine MUG’un 1:16’lık dilüsyonundan 1.25 ml eklenir ve disklerin solüsyonu tamamen emmesi sağlanır. Bu şekilde her bir disk 0.78 µg MUG içermektedir. Diskler metal bir levhanın üzerine yerleştirilerek kurutulur. Diskler, ışıktan korumak amacıyla koyu renkli bir şişeye yerleştirilerek -20°C’de 1 yıl, +4°C’de bir ay saklanabilir.
III.-Kalite Kontrol
A- Pozitif kontrol: Escherichia coli ATCC 25922
B- Negatif kontrol: Klebsiella pneumoniae ATCC 13883 veya ATCC 27736
IV.-Yöntem
MUG tüp testi :
Bir tüpe 500µl MUG ayıracı konur. Test edilecek bakterinin kanlı agar veya EMB’de üremiş kültüründen 1 koloni alınarak MUG içeren tüpe ekimi yapılır. En az 2 saat 35°C’de inkübe edilir.
MUG disk testi :
MUG içeren disk steril bir petri kutusuna konur. Disk üzerine 1 damla distile su konarak nemlenmesi sağlanır (Fazla su konması testin yanlış negatif okunmasına yol açabilir). Öze yardımıyla test edilecek bakterinin kanlı agarda üremiş kültüründen 1 koloni alınarak disk üzerine ekimi yapılır. En az 2 saat 35°C’de inkübe edilir. Alternatif olarak MUG içeren disk bakteri kültüründe bir koloninin üzerine de konabilir ve 30 dakika 35°C’de inkübe edilir.
MUG plak testi :
Test edilecek bakterinin taze kültüründen bir koloni alınarak MUG içeren adi agara ekimi yapılır. Plaklar 35°C’de en az iki saat inkübe edilir.
V.-Sonuçların Değerlendirilmesi

İnkübasyon dönemini takiben test tüpleri, diskler veya MUG içeren adi agar plakları UV lambası (366 nm) altında karanlık ortamda incelenir. Pozitif test mavi-beyaz floresan verirken, negatif testte floresan gözlenmez.

Disk metodunda değerlendirme yapılırken zayıf floresan gözlenmesi durumunda disk 2 ml serum fizyolojik içine konarak 10 dakika sonra tekrar değerlendirilir.
VI.-Kısıtlılıklar
- Tüm E.coli izolatları MUG pozitif olmayabilir. Bu nedenle negatif test sonucu bakterinin E.coli olmayacağını belirlemez.
- Disk testi için boya içeren besiyerleri (EMB, Mac Conkey gibi) kullanılmamalıdır.
- Shigella türleri indol pozitiftir ve %8’i MUG pozitiftir. Salmonella ve Yersinia’ nın nadir izolatları MUG pozitiftir. Ancak bu izolatlar nadir indol pozitiftir. Bu nedenle yanlış değerlendirmelere yol açmamak için abdominal veya kan kaynaklı laktoz negatif bakterilerde bu test çalışılmamalıdır.
- Bazı mikroorganizmalar (Pseudomonas aeruginosa gibi) floresan verir. Bu nedenle MUG testi oksidaz pozitif olan bakterilere uygulanmamalıdır.
Nitrat ve Nitrit İndirgenme Testi
I.-Prensip
Nitrat indirgenme testi bakterilerin tanımlanmasında rutin olarak kullanılmaktadır. Nitrat testi Enterobacteriaceae ailesi üyelerinin diğer gram-negatif bakterilerden ayrılması, Neisseria türlerinin ayrılması, Moraxella ve Kingella cinslerinin ayırımında önem taşımaktadır. Başta Corynebacterium olamak üzere sporsuz gram-pozitif bakterilerin tanımlanmasında kolaylıklar sağlamaktadır.
Bakteri nitratları nitrat redüktaz enzimi ile indirger. Nitratı indirgeyen bakteriler anaerobik solunum veya anaerobik kemolitrotrofi esnasında nitratı elektron alıcısı olarak kullanırlar. Nitrit çevre şartlarına ve bakterinin enzim sistemlerine bağlı olarak farklı bileşiklere indirgenir. Bunlar arasında azot monoksit, , nitröz oksit, amonyak ve azot gazı sayılabilir.
Nitritler, sülfanilik asit ve alfanaftilamin asit çözeltisiyle reaksiyona girerek kırmızı bir azo boyası oluşturur. Her test reaksiyonunda kırmızı boyanın görünümü, test tüpünde nitrit varlığını gösterir. Var olan nitrit test bakterisi veya çinko tarafından nitratın indirgenmesi sonucu veya indirmemiş halde besıyerine katılan olabilir. İndirgenme testlerinde amaç nitriti tanımlamadır.
II.-Besiyerleri ve Ayıraçlar
Bu amaçla kullanılan çeşitli besiyerleri vardır. Seçilen besiyerinde bakterinin fermente edeceği karbonhidratlar bulunmamalıdır. Aşağıda besiyeri ve reaktiflerin formülleri verilmektedir. Kalp infüzyon besiyerine %0,1 oranında potasyum nitrat ve potasyum nitrit katılarak da kullanılabilir.
| Nitrate reduction medium | Nitrite reduction medium | |
| Beef (meat) extract | 3 g | 3 g |
| Gelatin peptone | 5 g | 5 g |
| Potassium nitrate (KNO3) | 1 g | |
| Potassium nitrite (KNO2) | 1 g | |
| Deionized water | 1 L | 1 L |
Her iki et suyu substratı için de malzemeleri dikkatlice tartın ve çözeltiye yavaşça ısıtın. Test tüplerine boşaltın ve ters çevrilmiş Durham tüpleri ekleyin. 121°C, 15 psi’de 15 dakika otoklavlayın. Otoklavın basıncı et suyunu Durham tüpüne itecektir. Kullanmadan önce soğutun. 4°C ila 10°C’de saklamak için buzdolabında saklayın. Raf ömrü yaklaşık 6 aydır. Şekil 3, 13 mm x 100 mm’lik bir tüpte 4 ml et suyunu göstermektedir.
Reaktif olarak A reaktifi, B reaktifi ve çinko tozu kullanılır.
| A Reaktifi | B Reaktifi | |
| N,N-Dimethyl-α-naphthylamine | 0,6 ml | |
| Acetic acid (5N) | 100 ml | 100 ml |
| Sulfanilic acid 0.8 g | 0,8 g | |
| Acetic acid (5N) | ||
| Glacial acetic acid (17.4N) | 287 ml | |
| Distile su | 713 ml | |
| Çinko tozu, nitrat ve nitrit içermeyen |
III.-Kalite Kontrol
A- Pozitif kontrol:
Pseudomonas aeruginosa nitratı azot gazına indirger.
Escherichia coli nitratı nitrite indirger.
Alcaligenes faecalis ve Neisseria lactamica nitriti indirger fakat nitratı indirgenez.
B- Negatif kontrol: Acinetobacter baumanii nitratı ve nitriti indirgemez.
IV.-Yöntem
Saf olarak üretilmiş bakteri nitrat ve nitrit indirgenme besiyerlerine ayrı olarak ekilir. Etüvde 35°C sıcaklıkta 12 -24 saat inkübe edilir. Yeterli üreme saptandığı zaman test tüpü ve reaktifler kullanılır.
V.-İndirgenme Testleri ve Sonuçların Değerlendirilmesi

(1)Bakteri ekili olmayan veya nitratı indirgeyemeyen bakteri ekili olan besiyerine reaktif ilavesi renk değişimine neden olmaz. (2)Aynı besiyerine çinko tozu ilave edilir ise kırmızı renk değişimi meydana gelir.

(1)Nitrat ve nitrit besiyerinde üreme sonucu gaz oluşması Durham tüplerinde kabarcıklar halinde görülmektedir. (2)Aynı besiyerlerinden alınan 1 ml bakteri süspansiyonun içinde A ve B reaktifi olan test tüplerine ilave edilmesi sonucu renk değişimi gözlenmemektedir. Nitrit indirgenmesi vardır, nitrat indirgenmesi tam olarak belli değildir. (3)Nitrat test tüpünün içine çinko ilavesi sonucu renk değişimi gözlenmemiştir. Nitrat indirgenmesi vardır.


(1)Nitrat ve nitrit besiyerlerinde üreme görülmektedir. Gaz oluşumu yoktur. (2)A ve B reaktiflerin olduğu test tüplerine bakteri aktarıldığı zaman her iki tüpte de kırmızı renk görülmüştür. Her iki test tüpünde de nitrit vardır. Nitrat nitrite indirgenmiştir, nitrit olduğu gibi kalmış yani indirgenmemiştir.

(1)Nitrat ve nitrit besiyerlerinde üreme görülmektedir. Gaz oluşumu yoktur. (2)Bakterilerin test tüplere ilavesi sonucu her iki test tüpünde de renk değişimi olmamıştır. Nitrit indirgenmesi vardır. Nitrat indirgenmesi olup olmadığı çinko ilavesine bağlıdır. (3)Çinko ilavesi ile nitrat test tüpünde renk değişimi vardır. Nitrat indirgenmesi yoktur.
Nitrat İndirgenme Testi
- Durham tüplerinde gaz oluşumuna bakılır.
- Küçük bir tüp (12 mm x75 mm) içine A ve B reaktiflerinden ikişer damla damlatılır.
- Nitrat indirgenme besiyerinden yaklaşık 1 ml alınarak reaktiflerin damlatıldığı küçük tüpe aktarılır ve karıştırılır.
- Test edilen bakteri nitratları nitrite indirgiyor ise 2 dakika içinde kırmızı renk oluşur.
- Bu sonuç indirgenmeyi ve tüp içinde nitrit olduğunu gösterir.
- Kırmızı renk görülmediği zaman üç olasılık vardır.
- A.-Nitrat indirgenmemiştir, Negatif Reaksiyon
- B.-Nitrat nitrite indirgenmiştir fakat oluşan nitrit daha sonra nitrik oksit ve daha sonrada nitroz oksit ve daha da ilerde nitrojen gazına dönüşmüştür.

- C.-Nitrit doğrudan nitrojen gazına dönüşmüştür.

- Çinko kuvvetli bir indirgeyici ajandır. Negatif olarak saptanan tüp içine biraz çinko tozu döküldüğü zaman kırmızı renk oluşuyor ise tüp içinde nitrat kaldığını ve bakteri tarafından indirgenmediğini gösterir. Bu 6A hipotezinin doğrulanmasıdır. Nitrat ve nitrit içermeyen çinko tozu ince tahta bir çubuk ile alınarak test tüpüne batırılır. Fazla çinko alınması oluşan rengin hızla kaybolmasına neden olur.
- Eğer test tüpüne çinko eklendikten sonra renk oluşmamış ise renksiz kalırsa, bakterinin nitriti ara ürünlere ve nitrojen gazına dönüştürüp dönüştürmediği test edilmelidir. Durham tüpünde gaz var ise nitrojen gazının oluştuğunu göstermektedir. Bu 6B ve 6C hipotezinin doğrulanmasıdır.
Nitrit İndirgenme Testi
- Durham tüplerinde gaz oluşumuna bakılır.
- Küçük bir tüp (12 mm x75 mm) içine A ve B reaktiflerinden ikişer damla damlatılır.
- Nitrit indirgenme besiyerinden yaklaşık 1 ml alınarak reaktiflerin damlatıldığı küçük tüpe aktarılır ve karıştırılır.
- Test edilen bakteri nitritleri indirgiyor ise renk değişimi gözlenmez. Nitrit indirgenme besiyeri yerinde var olan nitritin çeşitli bileşiklere indirgendiğini gösterir. Nitrit nitrik oksit ve daha sonrada nitroz oksit ve daha da ilerde nitrojen gazına dönüşmüştür.

- Durham tüpünde gaz var ise nitrojen gazının oluştuğunu göstermektedir. Gaz yok ise nitritin farklı ürünlere dönüştüğü anlaşılır ama sonuç olarak nitrit indirgenmiştir.
- Test tüpünde kırmızı renk oluşuyor ise nitrit varlığını ve bakterinin nitriti indirgemediğini gösterir. Test sonucu negatiftir.
- Küçük test tüpünde pembe bir rengin görülmesi kısmen indirgenmenin varlığı gösterir. Bu durumda bakteri ekili olan orjinal nitrit indirgenme besiyeri tekrar inkübe edilerek süre sonunda test tekrarlanır.
KARBONHİDRAT OKSİDATİF-FERMENTATİF TEST
I.-Prensip
Oksidatif-fermentatif test, gram-negatif bakterilerin karbonhidratları fermentasyon veya oksidatif yol ile metabolize edip etmediğini saptamaya yöneliktir. Bazı bakteriler karbonhidratları her iki yol ile de metabolize ederken sakrolitik olmayan bakteriler ise her iki yolu da kullanmazlar.
Fermantasyonda son elektron alıcısı olarak organik bir bileşik görev yapar. Fermentasyon sonucunda bir asit veya asitle birlikte gaz oluşur. Ortaya çıkan son ürün fermente edilen substrata, enzimlere, pH ve ısı gibi faktörlere bağlı olarak değişir. Bakteriyel fermantasyon sonucu sıklıkla ortaya çıkan ürünler olarak laktik asit, formik asit, asetik asit, bütirik asit, bütil alkol, aseton, etil alkol, karbondioksit ve hidrojen sayılabilir. Fermantasyon reaksiyonları sonucu ortaya çıkan asit ürünler ortamın pH değerini değiştirir. Bu değişiklik bir renk indikatörü kullanılarak göz ile görülebilir hale getirilebilir.
Bazı nonfermentatif gram-negatif bakteriler glikozu aerobik solunum kullanarak Krebs döngüsü ve Entner Doudoroff (glikoliz) yoluyla metabolize ederler. Bu yolaklar sonucu az miktarda zayıf asit üretirler. Ortamdaki glikoz konsantrasyonunu artırarak zayıf asit üretiminin pH indikatörü ile saptanabilecek seviyeye getirilebilir. Bu zayıf asitlerin tespitini daha da artırmak için, besiyerine konulan pepton miktarı azaltılır. Bu sayede aminoasitlerin metabolize edilmesi sonucu oluşan amin miktar azalmış olur. Aminler miktarının azaltılması asitlerin nötralize edilmesi üzerine negatif etki yaratır. Asit tespitini daha da desteklemek için dipotasyum fosfat tamponu eklenir.
II.-Besiyerleri ve Ayıraçlar
| Hugh ve Leifson OF besiyeri | |
| Peptone (tryptone) | 2g |
| Sodyum klorür | 5 g |
| Glucose* | 10 g |
| Bromthymol blue | 0,03 |
| Agar | 3 g |
| Distile su | 1 L |
| Dipotassium phosphate | 0,3 g |
| Besiyerinin pH değeri 7,1 ± 0,2 olmalıdır. | |
| *Sadece kaynatılarak ise toz halinde kullanılır. |
Besiyeri pH değeri 7,1’e ayarlanır ve otoklavda 121°C’de 15 dakika steril edilir. Hafif soğuduktan sonra, filtre ile steril edilmiş, %10’luk karbonhidrat çözeltisinden son konsantrasyon %1 olacak şekilde aseptik olarak eklenir. Besiyerleri test tüplerine aseptik olarak dağıtılır. Test tüplerinin dik olarak soğuması beklenir.
Alternatif olarak tüm içrek distile suya konduktan ve distile su mikatrı 1 litreye tamamlandıktan sonra 10 gram karbonhidrat eklenir. Besiyeri 20 dakika buhar ile veya sıcak bir plak üzerinde kaynatılır. Besiyeri biraz soğuduktan sonra tüplere dağıtılır. Tüpler 20 dakika buhar ile veya sıcak bir plak üzerinde kaynatılır. Daha sonra dik bir şekilde soğumaya bırakılır.
III.-Kalite Kontrol
A.-Pozitif Kontrol :Escherichia coli, Pseudomonas aeruginosa.
B.-Negatif Kontrol :Alcaligenes faecalis.
IV.-Yöntem
Her bir bakteri için iki adet OF besiyeri kullanılır. Bakteriler besiyerlerine iğne öze kullanılarak ekilir. Ekim tabandan 0,5 cm yukarıya veya yüksekliğin yarısına kadar yapılır. kadar yapılır. Tüplerden birisinin üzerine 1 cm yaklaşık 1 cm kalınlığında steril mineral yağı konulur. Gram-negatif bakteriler 35°C’de 48 saat inkübe edilmelidir. Geç üreyen bakteriler 3-4 gün inkübe etmek gerekebilir.
V.-Sonuçların Değerlendirilmesi

Glikozu fermente edebilen bakteriler, hem açık (aerobik) hem de yağla kaplı (anaerobik) tüpte fermentasyon ürünü olan asitlerin ortam pH değerini değiştirmesi ile renk değişikliği gözlenir. Üretilen asit indikatörün rengi yeşilden sarıya değiştirir. Hareketli olan bakteriler ekim hattından uzaklara yayılan bulanıklığa neden olur.

Non-fermentatif bakteriler glikozu oksidatif yolu kullanarak metabolize ederler. Mineral yağı olmayan OF test besiyerinde üst kısımlarda renk değişikliği gözlenir. İnkübasyon süresinin uzaması sonucu azaltılmış pepton ve agar etkisi nedeniyle zayıf asit dolaysıyla değişikliğin tüm test tüpüne yayılabilir. Yağ konulan tüpte hiçbir değişiklik gözlenmez.

Sakrolitik olmayan bakteriler negatif OF sonucu verir. Negatif sonuç, yağla kaplı tüpte renk değişimi olmaması ve bazı durumlarda peptonun parçalanması sonucu ortaya çıkan aminlerin pH artışına neden olması sonucu mineral yağı içermeyen tüpün üstünde mavilik ortaya çıkar.
Oksidaz Testi
I.-Prensip
Oksidaz testinin amacı, bakterilerde sitokrom oksidazın araştırmaktır. Sitokron oksidaz indofenol oksidaz olarak da bilinir. Bazı bakterilerde Elektron Transport Sisteminindeki son basamakta yer alan sitokrom oksidazın sitokrom C’yi katalize ederken oksijeni su oluşturmak üzere indirger.
Oksidaz testinde ayıraç olarak kullanılan tetra-metil-p-fenilendiamin dihidroklorür elektron vericisidir. Sitokrom C elektronları alarak reaktifi oksitler. Normal olarak renksiz olan reaktif oksitlendiği zaman indofenol mavisi rengini alır. Bu reaksiyon basamaklar halinde incelenebilir.

a) Normalde elektron açısından zengin indirgenmiş bir kimyasal olan Tetra-metil-p-fenilendiamin dihidroklorür
(TMPD), renksizdir.
(b) Bakterilerin bir kısmında var olan sitokrom oksidaz enzimini aynı anda , dört sitokrom c molekülünün her birinden bir elektron. alır ve onları okside eder.
(c)Bu reaksiyon sonrasında sitokrom C oksitlenmiş, sitokrom enzimi ise redüklenmiştir.
(d) Sitokrom oksidaz enzimi dört elektronu moleküler oksijene aktarır ve dört protonla birlikte iki su molekülü oluşturur.
(e) Elektron kaybederek okside olmuş olan sitokrom C molekülü ayıraç olarak konulanTMPD ayıracından elektron alarak eski haline geri döner. Elektron kaybederek okside olan TMPD bileşiği ise elektron kaybederek oksitlenir ve indofenol mavisi rengini alır.
II.-Besiyerleri ve Ayıraçlar
Kovac oksidaz reaktifi : Tetra-methyl-p-phenylenediamine dihydrochloride %1 suda çözeltisi.
Gordon ve McLeod reaktifi : Dimethyl-p-phenylenediamine dihydrochloride, %1 suda çözeltisi.
Gaby ve Hadley oksidaz reaktifi : 1% α-naphtholun 95% etanoldeki %1 lik çözeltisi, p-aminodimethylaniline oxalate %1’lik.
III.-Kalite Kontrol
A- Pozitif kontrol: Pseudomonas aeruginosa ATCC 27853
B- Negatif kontrol: Escherichia coli ATCC 25922
IV.-Yöntem ve Sonuçların Yorumlanması
Oksidaz testinde birçok şekilde yapılabilir. Test edilecek bakteriler koyun kanlı agar, çikolata agarı ve trypticase soy agar besiyerlerinde çoğaltılmış olmalıdır. Bu konuda uyarılara bakın. Antibiyotik içeren besiyerleri kullanılmamalıdır.
Filter Kağıdı Yöntemi-1
- Küçük bir filtre kağıdına %1 Kovac reaktifi damlatılır ve kurumaya bırakılır.
- Öze yardımı ile 18-24 saatlik taze kültürden alınan 1-2 koloni reaktif kurutulmuş alana sürülür.
- Renk değişimlerini gözlenir.
- Oksidaz testi pozitif olan bakterilerde bakteri sürülen alan 5-10 saniye içerisinde koyu mor renge döner. Bu dönüşüm 60-90 saniye gibi daha geç bir sürede ortaya çıkarsa geç oksidaz pozitifliği olarak yorumlanmalıdır. Renk dönüşmez ise veya 2 dakikadan sonra renk değişimi olursa test negatif kabul edilir.
Filter Kağıdı Yöntemi-2
- Öze yardımı ile 18-24 saatlik taze kültürden alınan 1-2 koloni alınarak kurutma kağıdına sürülür.
- Bakteri sürülen alana 1-2 damla %1 Kovac reaktifi damlatılır.
- Renk değişimlerini gözlenir.
- Oksidaz testi pozitif olan bakterilerde bakteri sürülen alan 5-10 saniye içerisinde koyu mor renge döner. Bu dönüşüm 60-90 saniye gibi daha geç bir sürede ortaya çıkarsa geç oksidaz pozitifliği olarak yorumlanmalıdır. Renk dönüşmez ise veya 2 dakikadan sonra renk değişimi olursa test negatif kabul edilir.
Doğrudan Petri Kutusu Yöntemi
- Bakterinin 18-24 saatlik taze kültürü kullanılır.
- Tek bir koloni üzerine 1-2 damla %1 Kovac reaktifi veya %1 Gordon ve McLeod reaktifi damlatılır.
- Renk değişikliklerini gözlenir.
- Kovac reaktifi kullanıldığı zaman, 5-10 saniye içerisinde koyu mor renge dönüşme pozitif olarak kabul edilir. Bu dönüşüm 60-90 saniye gibi daha geç bir sürede ortaya çıkarsa geç oksidaz pozitifliği olarak yorumlanmalıdır
- Gordon ve McLeod reaktifi kullanıldığında, koloninin 10-30 dakika içinde kırmızıya veya 60 dakika içinde siyaha dönüşmesi pozitif olarak kabul edilir.
- Bakteri kolonisi üzerinde renk değişikliği görülmemesi negatif olarak kabul edilir.
Tüp Oksidaz Testi
- Bakterinin yaklaşık 5 ml buyyon içeren tüp içinde 18-24 saatlik kültürü yapılır.
- Besiyerine 0,2 ml %1 α-naftol eklenir daha sonra 0,3 ml %1 paminodimetilanilin oksalat eklenir.
- Renk değişimlerini gözlenir.
- Tüp içindeki besiyeri 15-30 saniye içinde maviye dönüşür ise oksidaz pozitif kabul edilir. Renk değişim 2-3 dakika içinde mor şeklinde görülür ise gecikmeli oksidaz pozitif olarak kabul edilir. Oksidaz negatif olan bakterilerde renk değişimi görülmez.
V.-Test Resimleri

DİKKAT
- Oksidaz testinde kullanılacak reaktifler taze olmalıdır. Buz dolabında ve karanlık ortamda en fazla bir haftalık reaktifler kullanılabilir.
- Bakteri kolonileri alırken metal ekipman kullanılmamalıdır. Steril ahşap ve plastik ekipman kullanılmalıdır.
- Yüksek oranda şeker veya boya içeren besiyerlerinde çoğaltılmış bakteriler teste alınmamalıdır.
- Eski kültürler test için kullanılmamalıdır.
ONPG Testi
I.-Prensip
Laktozu fermente eden bakterilerde laktoz permeaz ve betagalaktosidaz enzimleri bulunur. Permeaz enzimi, laktozun bakteri hücresine girmesini sağlar ve betagalaktosidaz enzimi ile laktoz galaktoz ve glikoza ayrılır. Laktozu fermente etmeyen bakterilerde bu iki enzim bulunmamaktadır. Ancak bazı bakteri türlerinde permeaz enzimi bulunmamasına karşın betagalaktosidaz enzimi bulunmaktadır. Bu bakteriler laktozu geç fermente ettikleri için genellikle laktoz negatif olarak değerlendirilirler. ONPG (o-Nitrophenyl-β-D-galactopyranoside) deneyi bu tür betagalaktosidazları olan geç parçalayıcı bakterileri tanımlamaya yarayan bir testtir. ONPG bileşiği yapı olarak laktoza benzemektedir. Ancak laktozda bulunan glikoz yerine bu bileşikte o-nitrophenyl grubu bulunmaktadır. Bu test ile organizmada β-galaktosidaz enzim varlığı araştırılır. ONPG bakteri hücresine laktoza göre daha hızlı girer ve β-galaktosidaz enzimi ile hidrolizi sonucu galaktoz ve o-nitrofenol oluşur. ONPG renksiz bir bileşikken, hidroliz sonucu oluşan o-nitrofenol sarı renktedir.
II.-Besiyerleri ve Ayıraçlar
| Monosodyum fosfat solüsyonu, 1 M, pH 7 | |
| Na2HPO4.H2O | 6,9 g |
| Distile su | 45 mL |
| NaOH, %30 (w/v) | 3 mL |
| o-Nitrophenyl–D-galactoside (ONPG), 0,0133 M | |
| ONPG | 80 mg |
| Distile su, 37°C | 15 mL |
| Monosodyum fosfat solüsyonu, 1 M, pH 7 | 5 mL |
A- Pozitif kontrol: Escherichia coli ATCC 25922
B- Negatif kontrol: Proteus mirabilis ATCC 29245
IV.-Yöntem
Test edilecek bakteri TSI besiyerine veya %1 laktoz içeren Nutrienet agara ekilir ve 18 saat 37°C derecede inkübe edilir. Steril tüp içine 0,25 ml serum fizyolojik konulur ve bir öze dolusu bakteri alınıp karıştırılır. Her tüp içine 1 damla toluen eklenir ve çalkalanır. Enzimlerin ortaya çıkması tüpler 5 dakika 37°C derecede bekletilir. Daha sonra tüplere 0.25 ml tamponlanmış 0.0133 M ONPG solüsyonu eklenir. Tüpler 35-37°C ısıda 24 saat inkübe edilir.
V.-Sonuçların Değerlendirilmesi

ONPG hücre içine girmek için permeaz enzimine gerek duymaz. Hücre içine girince betagalaktosidaz tarafından parçalanarak galaktoz ve o-nitro fenole ayrıştırılır. o-nitro fenol bileşiği sarı renktedir.
Deney sonucunda süspansiyonun renginin sararması bakterilerde betagalaktosidaz enziminin bulunduğunu işaret etmektedir.
ONPG’nin hidroliz hızı bakteriler arasında değişkenlik gösterebilir. Bazı organizmalar sarı rengin oluşmasını 5-10 dakikada sağlayabilir. Pozitif testlerin büyük çoğunluğu 1 saat içinde belirgin olur.
Ancak teste negatif denmesi için 24 saatlik inkübasyon şarttır.
